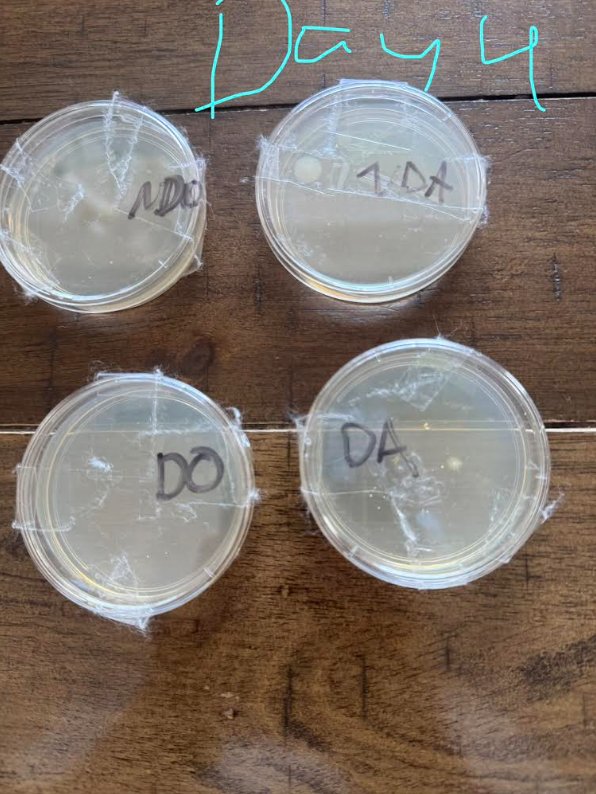
Image

5 second theory
Armaan Grewal, Soham Thakkar
Fairview School
Grade 5
Presentation
Hypothesis
We think bacteria will grow on the apple (that was dropped on the ground) because we think bacteria reproduce and spread faster than 5 seconds.
Research
Most bacteria love being warm, especially at "body temperature" (around 37°c). Bacteria need moisture to stay alive. Even though they are fast, it usually takes 2 to 5 days for their colonies to become large enough for the naked eye to see. Fun Fact: There are far more bacteria in your mouth than people in the world.
Variables
Manipulated variable/Independent variable: The apple slice ( one on the floor, one not ) Responding variable/Dependent variable: The amount of bacteria Controlled variable: Type of apple,
Procedure
Materials: Apple( 2 slices ) / (or any other food of your choice), microscope, time, cotton swab, water, pipette, agar plate, the floor, box, cotton, tape, Graduated beaker (5mL)
Step 1: Get all the materials in front of you. Step 2: Add water to the graduated beaker. Step 3: Drop the apple (or any other food of your choice) on the floor for 5 seconds, keep one slice of an apple with you and do not drop it. Step 4: Use the pipette and add some water to the cotton swab, and add about 3-5 drops. Step 5: Grab the cotton swab and rub the apple 360° Step 6: Then grab the cotton swab you used on the apple and gently rotate it 360° 4-6 times (please note that agar is very delicate, and if too much pressure is applied, the agar might crack) Step 7: Close the agar plate and take 3-4 pieces of tape and attach them horizontally onto the agar plate Step 8: Get some cotton and the box, and add cotton to the bottom of the box. Then, put the agar plates in it and then cover it with cotton (keep a few holes left for air to travel in). We need to do this because all living things need air to live, and bacteria are living things.
Observations
DAY:4
Day 8
Day 8 Final day: Day 14
Final day: Day 14
Analysis
Day 4:
NDO: No changes DO: No changes NDA: 1 medium-sized good bacteria colony DA: Lots of really small, bad bacteria colonies, 1 small good bacteria colony
Day 8:
NDO: extremely small, bad bacterial colonies DO: 1-3 extremely small, bad bacterial colonies NDA: extremely large, good bacterial colonies DA: lots and lots of small, bad bacteria colonies and 1 medium, good bacteria colony
Final day:
NDO: some good bacterial colonies DO: 1-2 orange and yellow (bad bacterial colonies), 4-5 good bacterial colonies NDA: extremely large, good bacterial colonies DA: tons of medium-sized bad bacterial colonies
Conclusion
There are a lot of yellow colonies of bacteria (bad bacteria colonies) on the DA/dropped apple agar plate because it was dropped on the floor, and because of the bacteria in the air.
There are a lot of white colonies of bacteria(good bacteria colonies) on the NDA/not dropped apple agar plate, because there is a chance that the apple was so fresh, and all the massive colonies have good bacteria
Application
Everyone in the world can use this information. Our idea can improve human health; for example, 90% of people we know use the 5-second rule, so now they'll know it's safe. Food Industries can create safe chemicals that can extend the 5-second rule to 10 secs so if people are busy and they drop their food, they will have more time to react. Health industries can create a medicine if the food someone was eating wasdropped on the ground and too much bad bacteria got on it, doctors can create a medicine accordingly, which can benefit all people. This research can lead to further studies because scientists can test this theory with different foods.
Sources Of Error
- We think we should try a variety of foods.
- The air also has bacteria, and the bacteria from the air can get on the apple/orange, which doesn't make it 100% accurate.
- Mark more dates
- Drop on 2 different areas,
- Don't let our hands touch the apple/orange
- Keep it somewhere warmer
Citations
- https://www.omegahospitals.com/blog/understanding-typhoid-causes-symptoms-prevention-and-treatment/
- https://www.atcc.org/resources/culture-guides/bacteriology-culture-guide
- https://www.youtube.com/watch?v=AMTtHVQmnsE&t=284s
- https://bio.libretexts.org/Courses/Ohio_State_University/Microbiology_Lab_SP25/01%3A_Lab_1/1.04%3A_Prokaryotic_Cells
- https://bio.libretexts.org/Workbench/BIOL-11B_Clovis_Community_College/03%3A_Prokaryotes/3.03%3A_Prokaryote_Characteristics?utm_source
- https://pmc.ncbi.nlm.nih.gov/articles/PMC4425030/#:~:text=Abstract,in%20human%20health%20and%20 diseases.
Acknowledgement
We acknowledge Armaan's family ( Armaan's Sister, Mom, and Dad), Soham's family (Soham's Sister, Mom, and Dad), Neel, Lucas(our friends), and Mr. Jassar (our science and math teacher) ( sorry we couldn't get them up in Attachments)
Our logbook Images 9

Our logbook Images




